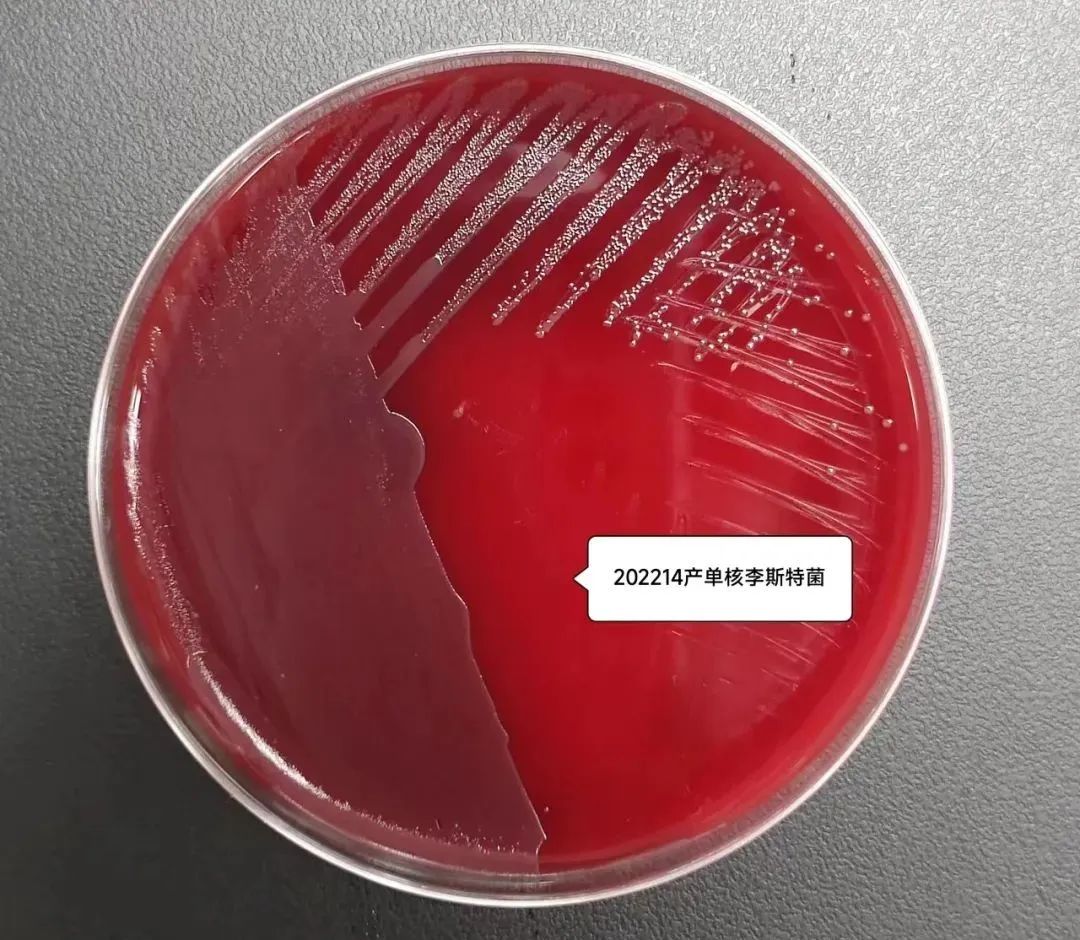
微信图片_20220802135245.jpg

盛夏季节,冰箱里的冷饮冷食无疑就会成为大多数人钟情的消暑食品。然而冰箱不是“保险箱”,很多食物会在其中滋生细菌和致病菌,夏季尤其需要防范号称“冰箱杀手”的李斯特菌。
今天,我们一起了解一下这个潜伏在我们身边的“隐藏杀手”。

李斯特菌生命力旺盛,对环境的适应能力强:耐冷、耐酸、耐盐,在绝大多数食品中都能找到李斯特菌。肉类、蛋类、禽类、海产品、乳制品、蔬菜等都已被证实可能是李斯特菌的感染源。该菌在冰箱中仍可生长繁殖(具有冷增殖的能力),是冷藏食品威胁人类健康的主要病原菌之一。在美国食品卫生监督局(FDA)的“杀手榜”中,李斯特菌年年榜上有名。在食源性感染中,李斯特菌引起的感染死亡率排名第三(16%),仅次于创伤弧菌(35%)、肉毒杆菌(17%)。
李斯特菌的特点

该菌能在2℃到零下42℃冷藏及冷冻冰箱中较长时间生存和生长繁殖;
生存适应范围大:在自然界广泛存在,可见于土壤、水、植物和一些动物的粪便中,并且可以污染食物,且在酸性、碱性条件下都适应生存;
带菌较高的食品有:牛奶和乳制品;肉类(特别是牛肉);蔬菜;沙拉;海产品;冰淇凌等;
季节性特点:春季可发生,而发病率在夏、秋季呈季节性增长。

主要以食物为传染媒介,是最致命的食源性病原体之一;
可通过眼及破损皮肤、粘膜进入体内而造成感染;
孕妇感染后通过胎盘或产道感染胎儿或新生儿;
栖居于阴道、子宫颈的该菌也引起感染,性接触也是本病传播的可能途径,且有上升趋势。
临床表现

成人个体出现轻微类似流感症状,可发热、恶心、呕吐、腹泻及关节肌肉疼痛等。新生儿、孕妇、免疫缺陷患者表现为呼吸急促、呕吐、出血性皮疹、化脓性结膜炎、发热、抽搐、昏迷、自然流产等,李斯特菌中毒严重者可引起血液和脑组织的感染,导致脑膜炎、败血症甚至死亡。
孕产妇(感染的危险度比健康成年人高20倍)、新生儿、婴幼儿、老年人、抵抗力差的免疫功能低下人群。在食入不洁食物后,如果出现发烧、腹泻、肌肉酸痛等明显感染症状,应及时去医院就诊。需送检微生物学检查时,要在抗菌药物使用之前,送检呕吐物、粪便等标本进行培养,怀疑发生血流感染时,及时抽取血培养,成人要求“双瓶双套”采集。
01一般细菌培养及鉴定+药敏
李斯特菌培养

李斯特菌涂片


氨苄西林与青霉素疗效最佳。红霉素、利福平、复方SMZ-TMP、氟喹诺酮类、克林霉素、万古霉素、氯霉四环素、头孢噻吩等也有效。治疗延误及严重新生儿败血症或脑炎病人常导致治疗失败。青霉素或氨苄西林联合氨基糖苷类对本菌常呈协同作用,败血症病人宜用药2周以上,脑膜脑炎疗程3周以上,心内膜炎4~6周,脑脓肿的疗程应超过6周。

加强饮食卫生,避免生吃各种肉类,蔬菜要冲洗干净,生熟砧板分开使用;
对冷藏后的食物一定要热熟热透,尤其是鱼、虾、肉类等;
加强锻炼,增加自身的免疫力,能够降低该菌的感染风险。
文 | 微生物部 张琳琼 陈玉芊
审校 | 徐修礼
编辑 | 曹星星
部分图片来源丨摄图网